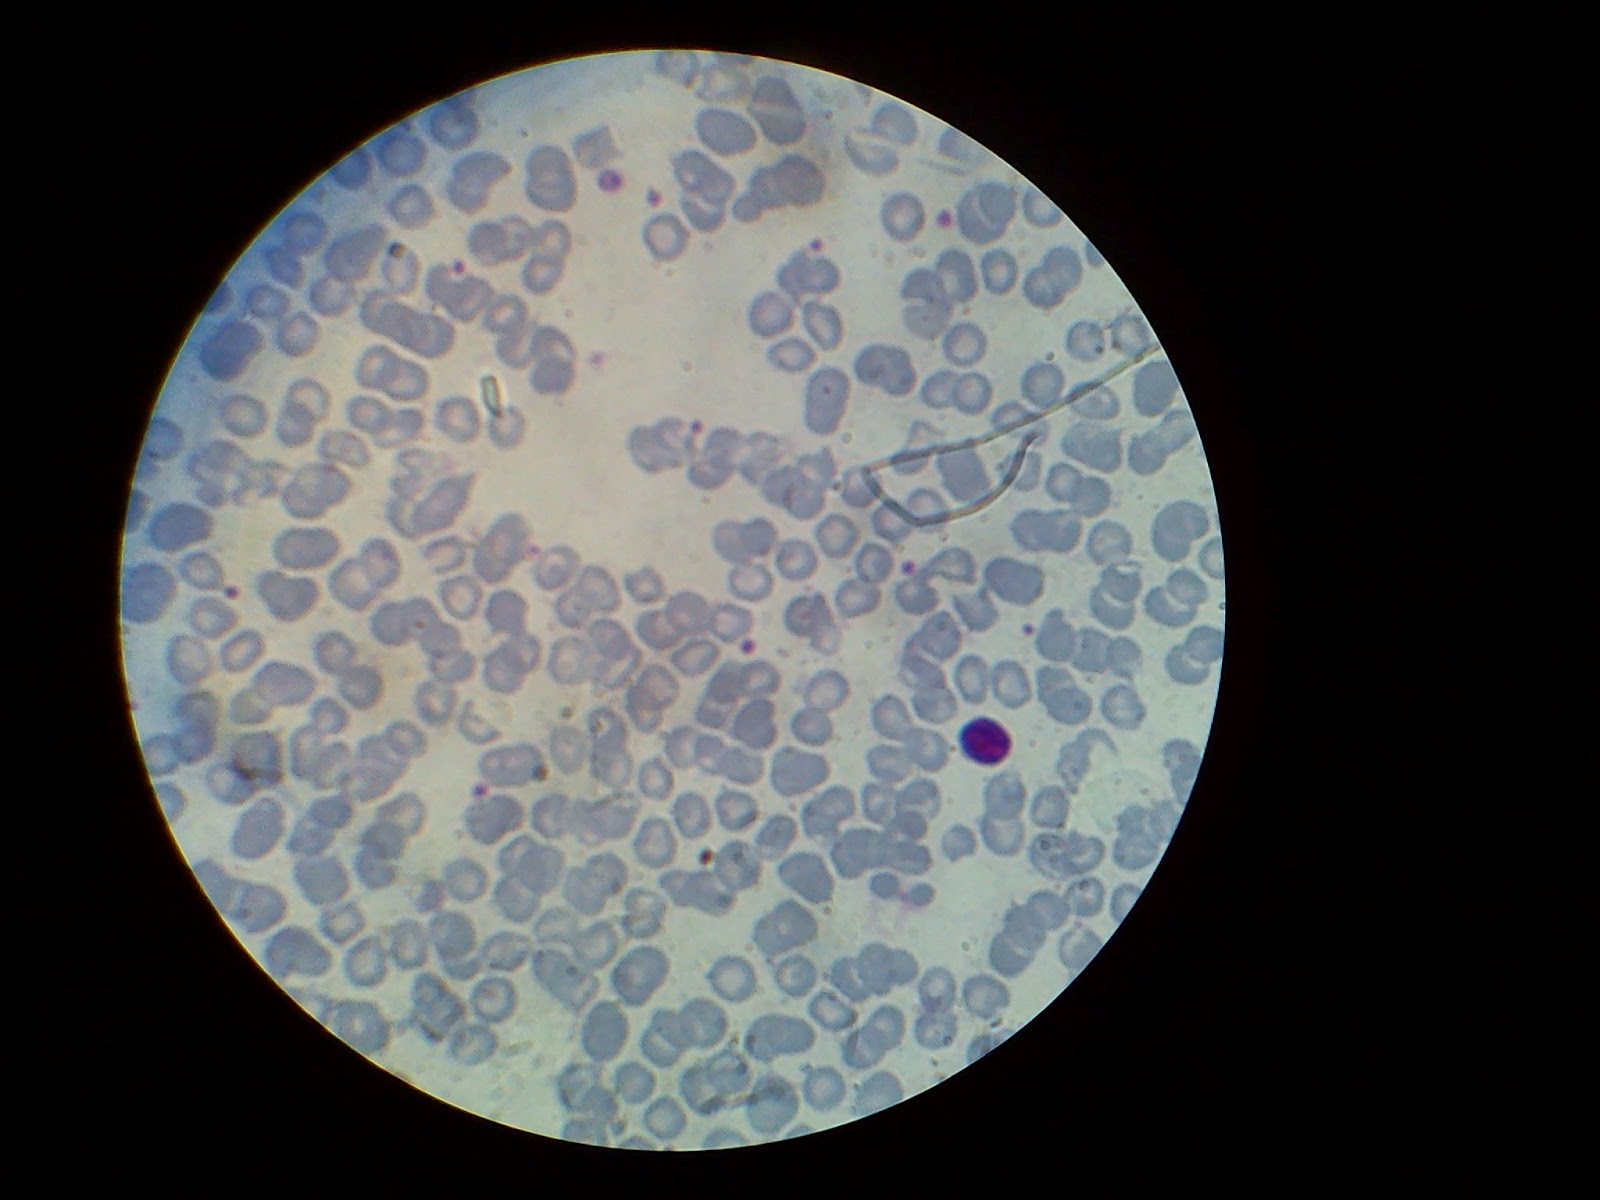

Pembahasan kimia un benzena dan turunannya.
Jika kamu mencari artikel pembahasan kimia un benzena dan turunannya terbaru, berarti kamu telah berada di web yang tepat. Yuk langsung saja kita simak penjelasan pembahasan kimia un benzena dan turunannya berikut ini.
 Soal Kimia Obyektif Kls Xi Hidro Karbon Dan Termokimia From tematiksoalku.blogspot.com
Soal Kimia Obyektif Kls Xi Hidro Karbon Dan Termokimia From tematiksoalku.blogspot.com
Tidak dapat menerangkan pengaruh medan magnet terhadap spektrum atom.
Benzena dengan rumus molekul c 6 h 6 adalah senyawa siklik dengan enam rantai karbon yang tergabung dalam cincin. Rumus struktur benzena menurut kekule menurut friedrich august kekule, jerman (1865), strukur benzena dituliskan sebagai cincin dengan enam atom karbon yang mengandung tiga buah ikatan tunggal dan tiga buah ikatan rangkap yang berselang seling. Rumus struktur senyawa benzena image via pandulive.blogspot.com. Bank soal un senyawa benzena dan turunannya. Bahan peledak dari senyawa turunan benzena adalah tnt, yaitu tri nitro toluena.
 Source: urip.info
Source: urip.info
Soal laju reaksi dan pembahasannya. Benzena (c6h6) adalah senyawa induk dari golongan besar zat organik ini. Dalam turunan benzena juga ada istilah nantinya dikenal orto (o), meta (m), para (p) dan akan dibahas setelah artikel ini. Benzena dan turunannya, senyawa organik dan anorganik, karbohidrat, hidrokarbon, serta. Bank soal un senyawa benzena dan turunannya.
Benzil alkohol polar 4,0 g/100ml iv.
Kegunaan senyawa turunan benzena dengan rumus struktur. Dalam turunan benzena juga ada istilah nantinya dikenal orto (o), meta (m), para (p) dan akan dibahas setelah artikel ini. Bahan peledak dari senyawa turunan benzena adalah tnt, yaitu tri nitro toluena. Benzil alkohol polar 4,0 g/100ml iv.
 Source: urip.info
Source: urip.info
(1) soal ebtanas tahun 2001. Benzena dan turunannya, senyawa organik dan anorganik, karbohidrat, hidrokarbon, serta. Senyawa hidrokarbon alifatik adalah senyawa karbon yang rantai c nya terbuka dan rantai c itu memungkinkan bercabang. Kelarutan suatu senyawa berpengaruh pada kepolarannya, etil benzena merupakan senyawa non polar olehnkarena itu etil benzena tidak larut dalam air.
 Source: tematiksoalku.blogspot.com
Source: tematiksoalku.blogspot.com
Tidak dapat menjelaskan spektra atom hidrogen. Benzena dengan rumus molekul c 6 h 6 adalah senyawa siklik dengan enam rantai karbon yang tergabung dalam cincin. 36 ihwal proses pembuatan unsur Berdasar iupac, dalam penamaan benzene dan turunannya maka cincin benzene dianggap sebagai induknya , sama seperti rantai terpanjang dalam alkana, gugus fungsi lain yang terikat pada benzene dianggap sebagai cabang.
 Source: python-belajar.github.io
Source: python-belajar.github.io
Senyawa hidrokarbon alifatik adalah senyawa karbon yang rantai c nya terbuka dan rantai c itu memungkinkan bercabang. Senyawa hidrokarbon alifatik adalah senyawa karbon yang rantai c nya terbuka dan rantai c itu memungkinkan bercabang. Benzena dengan rumus molekul c 6 h 6 adalah senyawa siklik dengan enam rantai karbon yang tergabung dalam cincin. Benzil alkohol polar 4,0 g/100ml iv.
Senyawa hidrokarbon alifatik adalah senyawa karbon yang rantai c nya terbuka dan rantai c itu memungkinkan bercabang.
Soal un kimia 2019 no. Penataan nama senyawa turunan benzena sama seperti pada senyawa alifatik, ada tata nama umum (trivial) dan tata nama menurut iupac yang didasarkan pada sistem penomoran. Proses pembuatan unsur, senyawa karbon, benzena dan turunannya, identifikasi senyawa karbon, dan ; Soal ini menyangkut mengenai tata nama benzena dan pembahasan , turunan senyawa benzena, di dalamnya juga terdapat soal un tentang benzena. (1) soal ebtanas tahun 2001.
 Source: urip.info
Source: urip.info
Tidak dapat menerangkan pengaruh medan magnet terhadap spektrum atom. Ok, kali ini kita akan membahas mengenai contoh soal tentang benzena. Berdasar iupac, dalam penamaan benzene dan turunannya maka cincin benzene dianggap sebagai induknya , sama seperti rantai terpanjang dalam alkana, gugus fungsi lain yang terikat pada benzene dianggap sebagai cabang. Kegunaan senyawa turunan benzena dengan rumus struktur. Benzena dengan rumus molekul c 6 h 6 adalah senyawa siklik dengan enam rantai karbon yang tergabung dalam cincin.
Soal ini menyangkut mengenai tata nama benzena dan pembahasan , turunan senyawa benzena, di dalamnya juga terdapat soal un tentang benzena.
Pembahasan soal kimia un 2014 nomor 16 sampai dengan nomor 20 tentang: Artikel kimia kelas xii membahas segala aspek tentang benzena. (1) soal ebtanas tahun 2001. Etil benzena non polar tidak larut iii.
 Source: urip.info
Source: urip.info
Penataan nama senyawa turunan benzena sama seperti pada senyawa alifatik, ada tata nama umum (trivial) dan tata nama menurut iupac yang didasarkan pada sistem penomoran. Kegunaan senyawa turunan benzena dengan rumus struktur. Bank soal un senyawa benzena dan turunannya. Proses pembuatan unsur, senyawa karbon, benzena dan turunannya, identifikasi senyawa karbon, dan ;
 Source: tematiksoalku.blogspot.com
Source: tematiksoalku.blogspot.com
Rumus struktur senyawa benzena image via pandulive.blogspot.com. Tidak dapat menjelaskan spektra atom hidrogen. Soal dan pembahasan benzena dan turunanannya. Turunan benzena (bagian 1) turunan benzena (bagian 2) turunan benzena (bagian 3) b.
 Source: dapatkancontoh.blogspot.com
Source: dapatkancontoh.blogspot.com
Benzena (c6h6) adalah senyawa induk dari golongan besar zat organik ini. Kegunaan senyawa turunan benzena dengan rumus struktur. Etil benzena non polar tidak larut iii. Asam benzoat polar 0,34 g/100ml ii.
Pembahasan soal soal ujian nasional un sma ipa bidang studi kimia dengan materi pembahasan benzena dan turunannya yang meliputi.
Soal laju reaksi dan pembahasannya. Benzil alkohol polar 4,0 g/100ml iv. Etil benzena non polar tidak larut iii. Artikel kimia kelas xii membahas segala aspek tentang benzena. Benzena (c6h6) adalah senyawa induk dari golongan besar zat organik ini.
 Source: dapatkancontoh.blogspot.com
Source: dapatkancontoh.blogspot.com
Soal un kimia 2019 no. Penataan nama senyawa turunan benzena sama seperti pada senyawa alifatik, ada tata nama umum (trivial) dan tata nama menurut iupac yang didasarkan pada sistem penomoran. Senyawa tersebut lazim dikenal sebagai. Benzil alkohol polar 4,0 g/100ml iv. Benzena dan turunannya, senyawa organik dan anorganik, karbohidrat, hidrokarbon, serta.
Benzena dengan rumus molekul c 6 h 6 adalah senyawa siklik dengan enam rantai karbon yang tergabung dalam cincin.
Kelarutan suatu senyawa berpengaruh pada kepolarannya, etil benzena merupakan senyawa non polar olehnkarena itu etil benzena tidak larut dalam air. Soal laju reaksi dan pembahasannya. Benzena dan turunannya, senyawa organik dan anorganik, karbohidrat, hidrokarbon, serta. Bahan peledak dari senyawa turunan benzena adalah tnt, yaitu tri nitro toluena.
 Source: urip.info
Source: urip.info
Benzil alkohol polar 4,0 g/100ml iv. Jika kita gambarkan, struktur benzena adalah sebagai berikut: Benzena dan turunannya, senyawa organik dan anorganik, karbohidrat, hidrokarbon, serta. Tidak dapat menjelaskan spektra atom hidrogen.
 Source: dapatkancontoh.blogspot.com
Source: dapatkancontoh.blogspot.com
Soal un kimia 2019 no. Benzena (c6h6) adalah senyawa induk dari golongan besar zat organik ini. Senyawa hidrokarbon alifatik adalah senyawa karbon yang rantai c nya terbuka dan rantai c itu memungkinkan bercabang. Bahan peledak dari senyawa turunan benzena adalah tnt, yaitu tri nitro toluena.
 Source: python-belajar.github.io
Source: python-belajar.github.io
Kegunaan senyawa turunan benzena dengan rumus struktur. (1) soal ebtanas tahun 2001. Mulai dari sejarah, struktur, sifat fisis dan kimia, cara tata nama senyawa benzena,. Etil benzena non polar tidak larut iii.
Rumus struktur senyawa benzena image via pandulive.blogspot.com.
Tidak dapat menerangkan pengaruh medan magnet terhadap spektrum atom. Pembahasan soal kimia ujian nasional (un) tahun 2017 nomor 36 hingga dengan nomor 40 tentang: Senyawa hidrokarbon alifatik adalah senyawa karbon yang rantai c nya terbuka dan rantai c itu memungkinkan bercabang. Tidak dapat menjelaskan spektra atom hidrogen. Rumus struktur senyawa benzena image via pandulive.blogspot.com.
 Source: dapatkancontoh.blogspot.com
Source: dapatkancontoh.blogspot.com
Kegunaan senyawa turunan benzena dengan rumus struktur. Tidak dapat menjelaskan spektra atom hidrogen. Metil salisilat merupakan salah satu contoh turunan benzena terkandung didalam balsam gosok. Benzena dengan rumus molekul c 6 h 6 adalah senyawa siklik dengan enam rantai karbon yang tergabung dalam cincin. Soal ini menyangkut mengenai tata nama benzena dan pembahasan , turunan senyawa benzena, di dalamnya juga terdapat soal un tentang benzena.
Tidak dapat menjelaskan spektra atom hidrogen.
Pembahasan soal kimia ujian nasional (un) tahun 2017 nomor 36 hingga dengan nomor 40 tentang: Bahan peledak dari senyawa turunan benzena adalah tnt, yaitu tri nitro toluena. Metil salisilat merupakan salah satu contoh turunan benzena terkandung didalam balsam gosok. Rumus struktur benzena menurut kekule menurut friedrich august kekule, jerman (1865), strukur benzena dituliskan sebagai cincin dengan enam atom karbon yang mengandung tiga buah ikatan tunggal dan tiga buah ikatan rangkap yang berselang seling.
 Source: python-belajar.github.io
Source: python-belajar.github.io
Etil benzena non polar tidak larut iii. Penataan nama senyawa turunan benzena sama seperti pada senyawa alifatik, ada tata nama umum (trivial) dan tata nama menurut iupac yang didasarkan pada sistem penomoran. Turunan benzena (bagian 1) turunan benzena (bagian 2) turunan benzena (bagian 3) b. Pembahasan soal kimia ujian nasional (un) tahun 2017 nomor 36 hingga dengan nomor 40 tentang: Asam benzoat polar 0,34 g/100ml ii.
 Source: urip.info
Source: urip.info
Tata nama benzena dan turunan benzena. Benzena dengan rumus molekul c 6 h 6 adalah senyawa siklik dengan enam rantai karbon yang tergabung dalam cincin. Pembahasan soal kimia un 2014 nomor 16 sampai dengan nomor 20 tentang: Soal laju reaksi dan pembahasannya. Dalam turunan benzena juga ada istilah nantinya dikenal orto (o), meta (m), para (p) dan akan dibahas setelah artikel ini.
 Source: tematiksoalku.blogspot.com
Source: tematiksoalku.blogspot.com
Dalam turunan benzena juga ada istilah nantinya dikenal orto (o), meta (m), para (p) dan akan dibahas setelah artikel ini. Soal ini menyangkut mengenai tata nama benzena dan pembahasan , turunan senyawa benzena, di dalamnya juga terdapat soal un tentang benzena. Rumus struktur benzena menurut kekule menurut friedrich august kekule, jerman (1865), strukur benzena dituliskan sebagai cincin dengan enam atom karbon yang mengandung tiga buah ikatan tunggal dan tiga buah ikatan rangkap yang berselang seling. Turunan benzena (bagian 1) turunan benzena (bagian 2) turunan benzena (bagian 3) b. Metil salisilat merupakan salah satu contoh turunan benzena terkandung didalam balsam gosok.
Situs ini adalah komunitas terbuka bagi pengguna untuk menuangkan apa yang mereka cari di internet, semua konten atau gambar di situs web ini hanya untuk penggunaan pribadi, sangat dilarang untuk menggunakan artikel ini untuk tujuan komersial, jika Anda adalah penulisnya dan menemukan gambar ini dibagikan tanpa izin Anda, silakan ajukan laporan DMCA kepada Kami.
Jika Anda menemukan situs ini bagus, tolong dukung kami dengan membagikan postingan ini ke akun media sosial seperti Facebook, Instagram dan sebagainya atau bisa juga save halaman blog ini dengan judul pembahasan kimia un benzena dan turunannya dengan menggunakan Ctrl + D untuk perangkat laptop dengan sistem operasi Windows atau Command + D untuk laptop dengan sistem operasi Apple. Jika Anda menggunakan smartphone, Anda juga dapat menggunakan menu laci dari browser yang Anda gunakan. Baik itu sistem operasi Windows, Mac, iOS, atau Android, Anda tetap dapat menandai situs web ini.